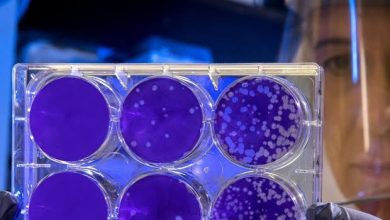

منوعات
انحناء العمود الفقري من المتاعب الصحية الشائعة

قال الاتحاد العام الألماني لجمعيات طب العظام إن انحناء العمود الفقري يعد من المتاعب الصحية الشائعة لدى كبار السن، موضحا أنه يرجع إلى أسباب عدة، على رأسها ضمور العظام والعضلات المرتبط بالتقدم في العمر؛ حيث يفقد الجسم بدءا من سن الأربعين حوالي %1 من كتلة العظام والعضلات سنويا.
وأضاف الاتحاد أن الأسباب تشمل أيضا فقدان الأقراص الفقرية لمرونتها، وكسور الجسم الفقري نتيجة لهشاشة العظام.
وأشار إلى أن انحناء العمود الفقري يؤدي إلى تقوس الظهر، مما يزيد من صعوبة المشي بشكل منتصب؛ حيث يكون الجسم مائلا إلى الأمام. ونتيجة لانحناء الهيكل العظمي عادة ما تتقوس البطن إلى الخارج.
وبشكل عام، تؤدي هذه التشوهات إلى تغيرات في وضعية الجسم وتصبح المشية أبطأ وغير مستقرة، مما يرفع خطر السقوط، ومن ثم التعرض للكسور، التي قد تؤدي إلى قيود حركية تؤثر بالسلب على جودة الحياة بسبب عدم القدرة على الاعتماد على النفس في الحر.